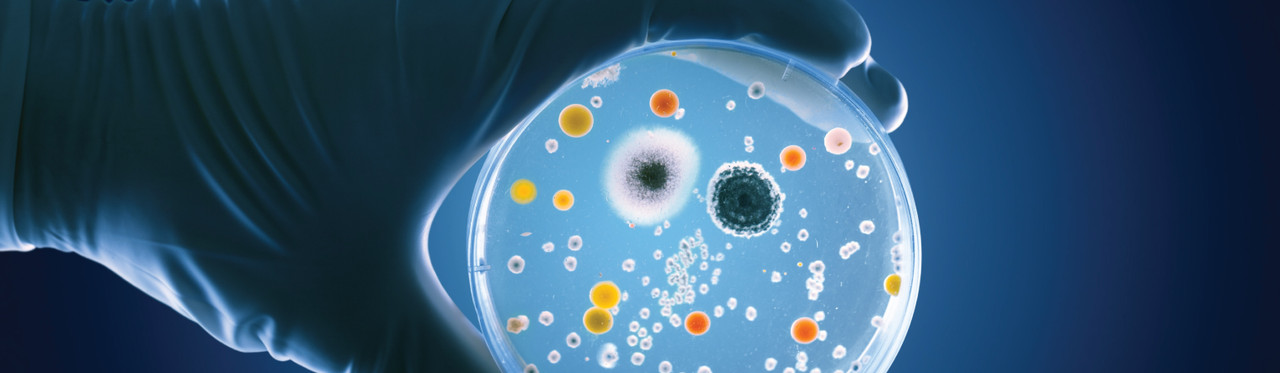
Beyond the Genome: Cancer’s Microbial Signature

What’s Inside Tumors Matters: How Microbial Signatures Are Transforming Cancer Research and Diagnostics
For years, cancer research has focused primarily on genetic mutations and cellular pathways. But new evidence suggests that another layer of biological complexity—the tumor microbiome—may play a critical role in how cancers develop, behave, and respond to treatment.
A recent large-scale study analyzing thousands of cancer genomes has revealed something unexpected: colorectal cancer carries a distinct microbial “fingerprint” that sets it apart from other tumor types.
For molecular biologists, clinical researchers, and laboratory professionals, this discovery opens new avenues in diagnostics, biomarker discovery, and precision medicine.
Inside the Study: Large-Scale Metagenomic Profiling Across 9,000+ Tumor Genomes
The study leveraged whole genome sequencing (WGS) data from over 9,000 tumor samples across multiple cancer types, enabling a comprehensive, cross-cohort analysis of microbial DNA signatures embedded within tumor sequencing datasets.
Rather than treating non-human reads as background noise, the researchers applied a metagenomic analysis framework designed to systematically identify and classify microbial sequences.
Analytical Approach
To ensure robustness and minimize false positives—one of the major challenges in tumor microbiome research—the team implemented a multi-step pipeline that included:
-
Rigorous decontamination filtering to exclude environmental and reagent-derived sequences
-
Alignment of non-human reads against curated microbial reference databases
-
Cross-validation across datasets to confirm reproducibility of microbial signatures
-
Statistical modeling to associate microbial presence with tumor type and clinical outcomes
This level of stringency is critical, given that low-biomass samples—such as tumor tissues—are particularly vulnerable to contamination artifacts.
A Distinct Microbial Signature in Colorectal Cancer
Among all cancer types analyzed, colorectal tumors exhibited the most consistent and distinguishable microbial profile.
Key observations included:
-
Enrichment of specific bacterial taxa previously associated with colorectal tumorigenesis
-
A reproducible microbial pattern capable of discriminating colorectal cancer from other malignancies
-
Greater microbial signal stability compared to other tumor types
In contrast, most other cancers did not display sufficiently distinct or consistent microbial signatures, suggesting that tumor–microbiome interactions may be highly tissue-specific.
This finding reinforces the hypothesis that the colorectal tumor microenvironment—directly exposed to the gut microbiota—creates unique conditions for microbial colonization and interaction.
Beyond Bacteria: Viral Detection and Oncogenic Associations
In addition to bacterial taxa, the study also identified viral sequences embedded within tumor genomes.
Notably, the analysis detected:
-
Human papillomavirus (HPV) in relevant tumor types
-
Human T-lymphotropic virus type 1 (HTLV-1) in select samples
These findings highlight the utility of WGS datasets as a dual-purpose resource, enabling simultaneous characterization of:
-
Host genomic alterations
-
Tumor-associated microbiota
-
Oncogenic viral integrations
For researchers working at the intersection of oncology and infectious disease, this reinforces the value of integrated genomic–metagenomic pipelines.
Clinical Correlations: Microbial Signatures and Patient Outcomes
Beyond classification, the study explored associations between microbial presence and clinical outcomes.
In certain cancers—such as sarcomas—specific microbial signatures were correlated with patient survival, suggesting potential prognostic relevance.
While causality remains to be established, these findings raise important questions:
-
Are these microbes actively influencing tumor progression?
-
Do they modulate immune response or therapy resistance?
-
Or are they biomarkers of underlying tumor biology?
As the authors note:
“Looking at the microbes in tumor samples could become a powerful tool for improving cancer care at little extra cost.”
Implications for Diagnostics and Precision Medicine
One of the most immediate applications of this research lies in diagnostics.
1. Improved Cancer Classification
Distinct microbial signatures could support:
-
More accurate tumor identification
-
Differentiation between cancer subtypes
-
Earlier and less invasive detection strategies
2. Prognostic Biomarkers
Associations between microbial presence and survival outcomes point to:
-
Microbiome-based risk stratification
-
Predictive markers for treatment response
3. Integrated Genomic-Microbial Profiling
As WGS becomes more common in clinical settings, microbial analysis could be incorporated with minimal additional cost—unlocking additional layers of insight from existing datasets.
What This Means for Molecular and Clinical Laboratories
This research has direct implications for lab workflows, instrumentation, and procurement decisions.
High-Sensitivity Sequencing Is Now Essential
Detecting microbial DNA within tumor samples requires:
-
High-depth sequencing
-
Low-background contamination
-
Robust library preparation methods
Even trace contamination can distort results, making reagent purity and workflow control critical.
Bioinformatics Pipelines Must Evolve
Laboratories will increasingly need:
-
Tools to separate host and microbial reads
-
Validated pipelines for metagenomic analysis
-
Integration of clinical metadata with sequencing outputs
Sample Integrity Is More Critical Than Ever
Because microbial signals can be subtle:
-
Sample collection and storage conditions must be tightly controlled
-
Cross-contamination risks must be minimized
-
Standardized protocols become essential in regulated environments
Expanding Research Opportunities
The identification of tumor-specific microbial signatures opens several high-impact research directions:
-
Microbiome-driven cancer mechanisms
-
Therapeutic targeting of tumor-associated microbes
-
Combination therapies integrating microbiome modulation
-
Next-generation diagnostics using multi-omic data
For molecular diagnostics labs, biotech R&D teams, and healthcare professionals, this reinforces a broader trend: multi-layered biological data is the future of precision medicine.
Bridging Innovation and Lab Readiness
As the role of microbial signatures in cancer becomes clearer, laboratories must adapt to support more complex, data-rich workflows.
This includes investing in:
-
High-quality sequencing reagents
-
Contamination-controlled consumables
-
Reliable sample handling systems
-
Scalable genomic and metagenomic solutions
At Pro Lab Supply, enabling this level of precision means supporting laboratories with tools designed for accuracy, reproducibility, and regulatory compliance in advanced molecular applications.
Final Thoughts
Cancer is no longer viewed solely as a genetic disease. It is increasingly understood as a multi-factorial system involving host biology, environmental inputs, and microbial ecosystems.
The discovery of a distinct microbial fingerprint in colorectal cancer marks a turning point—one that could reshape how we diagnose, monitor, and treat disease.
For modern laboratories, the message is clear:
The future of cancer research lies not just in the genome—but in everything that surrounds it.

Source
University of East Anglia. “What’s hiding inside colon cancer could change treatment.” ScienceDaily, April 1, 2026.